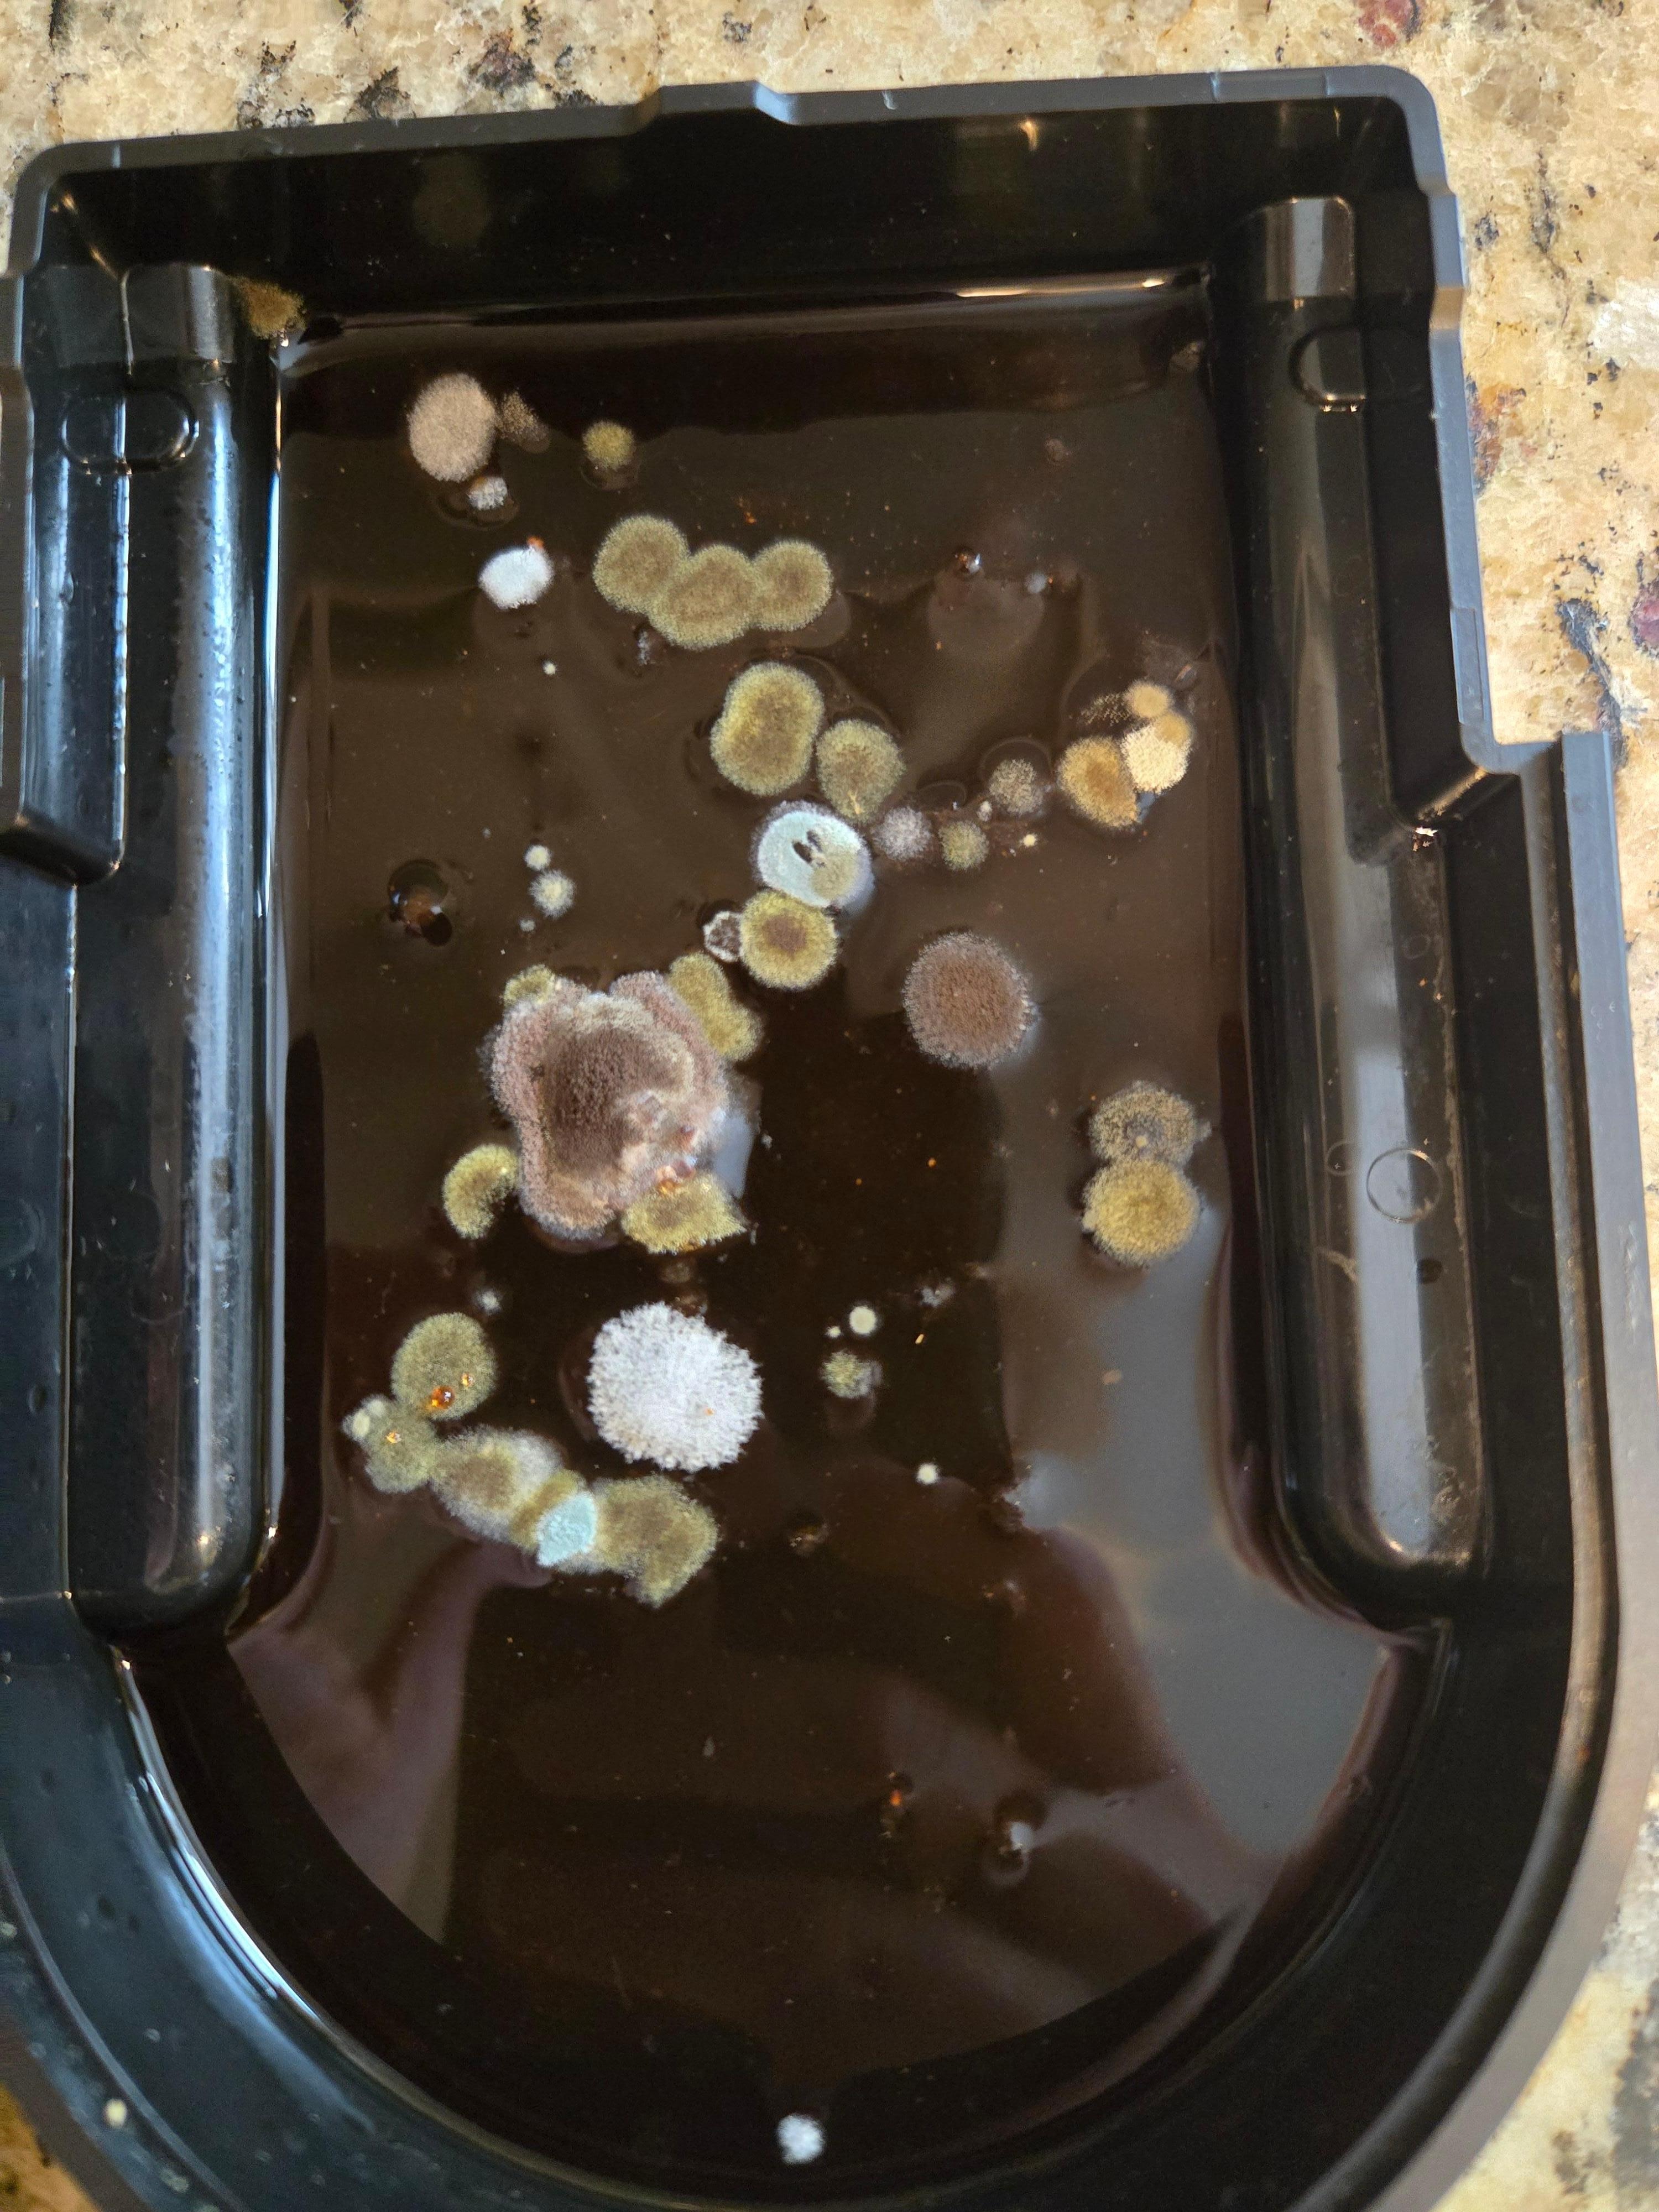

4/10 Poor
Reba H.
29 Oct 2025
TL;DR: the house is not in an "up and coming" neighborhood by any means. It's a very low-income area that left me feeling unsafe. Additionally, there are significant cleanliness/odor issues and property management had poor communication skills.I stayed here while working for 12d prior to closing on our home. The photos were lovely & I love being near the Swamp Rabbit to run. Unfortunately there are many issues with this home.Firstly, the day I arrived I couldn't access the home with the code provided. Laura, the manager who was supposed to be the emergency contact didn't have her phone on & didn't respond for about 90 minutes.Another issue is the low-income neighborhood. I don't mind a lower-income area itself, but this was to the point I felt unsafe staying there as a woman. I was chased down the street by loose dogs on 3 separate occasions, had men stop in the street across from me to gawk while I was walking my dogs, & even encountered a male prostitute one evening. The last issue is cleanliness. The house was overpoweringly scented with wall plugs, odor-eaters, & a strong cleaning solution when I arrived. After 5-6 days this wore off & there was a foul odor. I found old trash that had been shoved into the bottom of the can with a new bag over it, a moldy coffee maker/dishwasher, and dust galore and spent my weekend cleaning. I brought these concerns up to Laura, but was met w/ a lot of excuses and skepticism as if my complaints were a money-grab.

Reba H.
Stayed 12 nights in Oct 2025















